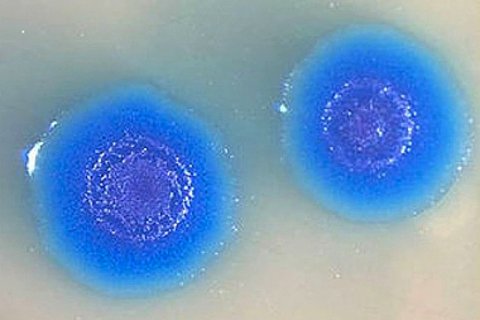

It didn’t help that Galileo would satirize and mock the Church hierarchy.
Arri Eisen
Arri Eisen is a Senior Lecturer in Biology for Emory University’s Center for Ethics and co-editor of Science, Religion, and Society: History, Cultures, and Controversies (M. E. Sharpe, 2007). His Science in Your Life radio spots, which aired on Atlanta’s NPR affiliate, can be found here.